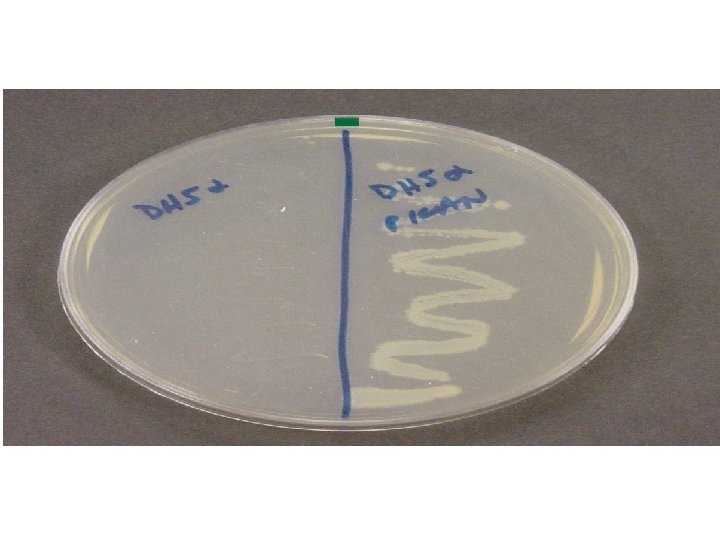

TRANSFORMACIN Fred Griffith 1928 sus estudios los realiz

- Slides: 33
TRANSFORMACIÓN
Fred Griffith 1928, sus estudios los realizó en Streptococcus pneumoniae Conclusión: Las células R “absorbieron” “algo” de las células S “principio transformante”
El Principio transformante es DNA
TRANSFORMACIÓN CAMBIO HEREDABLE EN UNA CÉLULA U ORGANISMO PRODUCIDO POR LA INTRODUCCIÓN DE UN DNA EXÓGENO Puede ser NATURAL (se han encontrado aproximadamente 40 especies que pueden realizar este proceso) ARTIFICIAL (INDUCIDA)
TRANSFORMACIÓN ¿Para qué tomar DNA exógeno? . . Grandes maquinarias proteícas intervienen en el proceso de transformación Algunas hipótesis que no son excluyentes…. . I. Para la diversidad genética (por ejemplo: obtener resistencia a antibióticos) II. Para la reparación de DNA III. Como nutrientes: El DNA es fuente de carbono, nitrógeno y fósforo
SEMEJANZAS Y DIFERENCIAS TRANSFORMACIÓN vs CONJUGACIÓN ¿existe DNA libre en todos los ambientes, es estable?
TRANSFORMACIÓN NATURAL, las bacterias más estudiadas son GRAM + GRAM - Streptococcus pneumoniae Neisseria gonorrhoeae Bacillus subtilis Haemophilus influenzae El proceso de transformación se puede dividir en 2 ETAPAS ETAPA 1: Desarrollo de un estado competente ETAPA 2: Procesamiento del DNA Unión Importe Recombinación
Etapa 1: Desarrollo de un estado competente ¿Qué es una célula competente? Estado fisiológico inducible Factores que inducen el estado de competencia en la transformación natural: Limitación en los nutrientes Mitomicina C Alta densidad celular Temperatura, p. H La transcripción de los genes com se inducen durante el estado de competencia Velocidad de transferencia: 90 -100 nucleótidos/segundo a 30°C
La transcripción de los genes com se inducen durante el estado de competencia
Transporte DNA en Gram + ANTES se debe formar el pseudopili que atraviesa la pared celular 1. Unión del DNA a la superficie por interacción con proteínas (++) del pseudopili 2. Unión a receptor: Com. EA (no es secuencia específica) 3. Fragmentar y degradar la cadena que no se transporta 4. Se ha encontrado una endonucleasa en membrana Com. EC: canal en la membrana Com. FA: unión a ATP
Transporte DNA en Gram + El pili debe cruzar la membrana interna, el espacio periplásmico y la membrana externa Se ha sugerido que el reconocimiento es secuencia específica: (5´GCCGTCTGAA-3´) Pili tipo IV: Sistema de secreción tipo II
Una vez que ingresó el DNA de cadena sencilla ¿qué ocurre dentro de la célula? ¿DE MANERA NATURAL es fácil intercambiar plásmidos entre bacterias por transformación? ¿es más fácil por conjugación?
TRANSFORMACIÓN ARTIFICIAL El “caballito de batalla” es la bacteria Escherichia coli Es una técnica fundamental en biología molecular: clonación y generar organismos transgénicos
TRANSFORMACIÓN: HERRAMIENTA ÚTIL EN EL CAMPO DE LA BIOLOGÍA MOLECULAR VECORES GENÉTICOS: molécula de DNA que es usada como vehículo para transportar segmentos de DNA foráneo en una célula huésped,
PLÁSMIDOS
OBJETIVO DE LA PRÁCTICA: OBTENER BACTERIAS RESISTENTES A KANAMICINA Escherichia coli Medio LB + KANAMICINA
En la transformación artificial ¿cómo se induce el estado competente de una bacteria? 1. Tratamiento químico 2. Electroporación
Preparar células competentes de E. coli A= 0. 6 – 0. 8 a 600 nm 3 m. L medio Luria Incubar toda la noche a 37°C
Preparar células competentes de E. coli 5000 r. p. m. 5 min 4°C 3 m. L Na. Cl 5 m. L Ca. Cl 2 Resuspende r CÉLULAS COMPETENTES Incubar 20 min 2500 r. p. m 7 min
LA TRANSFORMACIÓN SE REALIZARÁ POR CHOQUE TÉRMICO 42°C 70 s 1 hr Incubar a 37°C con agitación por 45 min 1 m. L medio SOC Inmediatamente en hielo
CÉLULAS COMPETENTES PLÁSMIDO: DNA EXÓGENO Buffer TE, Ca. Cl 2 y PLÁSMIDO
Al final de la transformación
Utilizaremos el plásmido p. ET-TEM Sitio múltiple de restricción Gen que confiere resistencia a kanamicina: kanamicina fosfotransferasa Origen de replicación
Enzimas inactivadoras de aminoglucósidos: La resistencia de las cepas se hace por síntesis de enzimas generalmente codificadas por plásmidos. La inactivación de los aminoglucósidos se hace por: 1. Adenilación de grupos hidroxilo. 2. Fosforilación de grupos hidroxilo. 3. Acetilación de grupos amino. ENZIMA INACTIVADORA AMINOGLUCÓSIDO INACTIVADO: Gentamicina adeniltransferasa Gentamicinas, Sisomicina, Kanamicinas, Tobramicina. Gentamicina acetiltransferasa Netilmicina, Tobramicina, Gentamicinas, Sisomicina. Kanamicina acetiltransferasa Netilmicina, Amikacina, Neomicina, Kanamicinas, Tobramicina, Gentamicinas, Sisomicina. Neomicina, Kanamicina fosfotransferasa Gentamicina A, Neomicina, Kanamicina
MECANISMO PROPUESTO PARA LA ENTRADA DE DNA EXÓGENO EN BACTERIAS COMPETENTES DE E. coli ANIMACIÓN
Células no transformantes Medio Luiria + KANAMICINA
ESQUEMA GENERAL SESIÓN I: TRANSFORMAR cepas de E. coli con un plásmido para que adquieran resistencia a un antibiótico SESIÓN 2: AISLAR el plásmido mediante la técnica de Lisis alcalina SESIÓN 3: FUNCIóN DE LAS ENZIMAS DE RESTRICCIÓN Cortar el plásmido aislado con enzimas de restricción y visualizarlo en un gel de agarosa teñido con bromuro de etidio